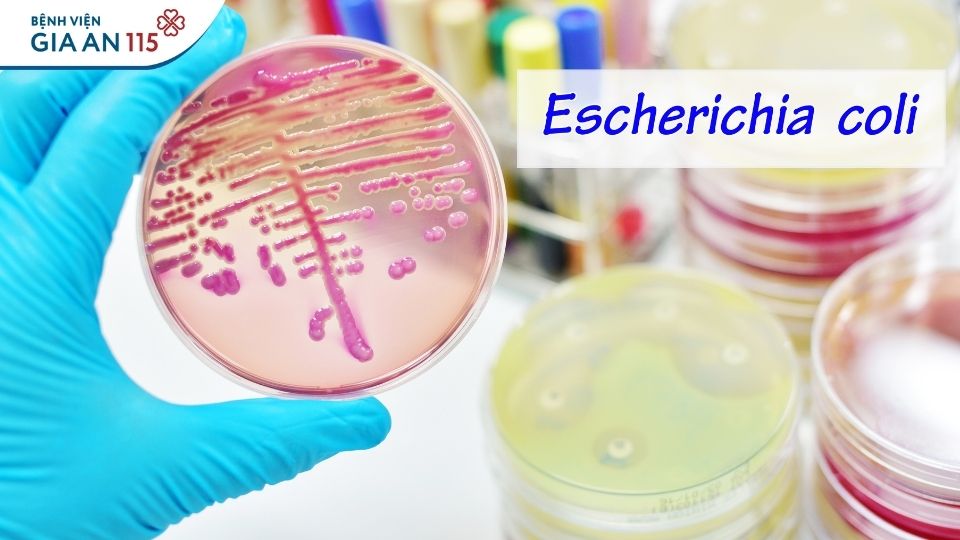
Uống nước máy trực tiếp An toàn hay tiềm ẩn rủi ro

Uống nước máy trực tiếp: An toàn hay tiềm ẩn rủi ro?
Nước máy đã được xử lý theo quy chuẩn, vậy có thể uống trực tiếp hay không? Ít ai biết rằng trên đường từ nhà máy đến vòi nước, chất lượng nước có thể thay đổi đáng kể. Theo chia sẻ của ThS.BS. Võ Thị Tố Hi – Trưởng khoa Dinh dưỡng, Bệnh viện Gia An 115, vẫn còn nhiều rủi ro tiềm ẩn nếu uống nước máy trực tiếp. Vậy đâu là nguy cơ và cách dùng nước máy an toàn?

Nguy cơ nếu uống nước máy trực tiếp
Chia sẻ của ThS.BS. Võ Thị Tố Hi – Trưởng khoa Dinh dưỡng, Bệnh viện Gia An 115, nước máy tại các đô thị lớn như TP.HCM thường được xử lý đạt Quy chuẩn kỹ thuật quốc gia về Chất lượng nước sạch sử dụng cho mục đích sinh hoạt (QCVN 01:2021/BYT). Tuy nhiên, quy chuẩn này chỉ đảm bảo cho mục đích sử dụng sinh hoạt thông thường, không phải để uống trực tiếp. Thực tế, dù nước đầu nguồn được xử lý đúng quy trình, nhưng khi đi qua hệ thống ống dẫn cũ, bể chứa hoặc vòi rửa, nước có thể bị tái nhiễm vi sinh vật (như E. coli, Giardia) hoặc nhiễm kim loại nặng (chì, đồng, kẽm). Ngoài ra, clo dư được sử dụng để khử khuẩn có thể phản ứng với các chất hữu cơ trong nước tạo ra trihalomethane (THMs) như chloroform – nếu tích tụ lâu dài, có thể ảnh hưởng đến gan, thận và tăng nguy cơ rối loạn nội tiết.
BS. Tố Hi cho biết, nước máy chưa đun sôi có thể chứa vi khuẩn gây bệnh đường ruột (E. coli, Salmonella), ký sinh trùng (Giardia, Cryptosporidium) hoặc các hóa chất tồn dư (clo, kim loại nặng, nitrat) từ hệ thống đường ống.
Tác động ngắn hạn:
- Gây rối loạn tiêu hóa (đau bụng, nôn, tiêu chảy).
- Clo dư có thể kích ứng niêm mạc ruột, làm giảm hoạt động của enzym tiêu hóa, gây khó hấp thu đạm và tinh bột.
Tác động dài hạn:
- Dễ dẫn đến viêm ruột mạn tính, mất cân bằng hệ vi sinh đường ruột, giảm hấp thu vi chất (sắt, kẽm, vitamin B12).
- Kim loại nặng như chì, asen có thể tích lũy, gây thiếu máu, rối loạn chuyển hóa xương, sỏi thận hoặc tổn thương thần kinh.
Một số đối tượng dễ bị tổn thương:
- Trẻ em: dễ mất nước, rối loạn điện giải, giảm hấp thu sắt và kẽm.
- Phụ nữ mang thai: nước có nitrat hoặc kim loại nặng có thể cản trở hấp thu folate, tăng nguy cơ dị tật thai nhi.
- Người cao tuổi: giảm chức năng thận, dễ bị mất nước, suy giảm điện giải, hoặc tích lũy độc chất lâu ngày.
Do đó, dù nước máy được kiểm soát chất lượng, vẫn không nên uống trực tiếp mà cần đun sôi hoặc lọc bằng thiết bị đạt chuẩn để loại bỏ clo dư, vi sinh vật và tạp chất, giúp bảo vệ hệ tiêu hóa và tránh tích tụ độc chất lâu dài.
Nước máy chưa đun sôi có thể chứa vi khuẩn gây bệnh đường ruột, ký sinh trùng hoặc các hóa chất tồn dư từ hệ thống đường ống (Ảnh minh họa)
Rủi ro nếu dùng nước máy trong bình nhựa tái sử dụng
ThS.BS. Võ Thị Tố Hi cho biết, bình nhựa tái sử dụng, đặc biệt là loại PET hoặc PP, nếu chỉ rửa thủ công mà không khử trùng kỹ bằng nhiệt độ cao (>70°C) hoặc tia UV, rất dễ tích tụ màng sinh học (biofilm) – môi trường thuận lợi cho vi khuẩn phát triển như E. coli, Pseudomonas.
Ngoài ra, khi bình nhựa bị phơi nắng hoặc tiếp xúc với nước nóng, các hợp chất như bisphenol A (BPA), phthalate hoặc antimony có thể được giải phóng, gây rối loạn nội tiết, tổn thương gan, thận hoặc ảnh hưởng khả năng sinh sản. Clo dư trong nước cũng có thể phản ứng với nhựa tạo ra chloroform, một hợp chất độc hại nếu tích tụ lâu dài.
Vì vậy, nên dùng bình thủy tinh hoặc bình nhựa đạt chuẩn an toàn thực phẩm (PET1, PC), tránh tái sử dụng quá nhiều lần và thay mới định kỳ theo khuyến cáo của nhà sản xuất.

Nên đựng nước uống trong bình thủy tinh hoặc bình nhựa đạt chuẩn an toàn thực phẩm
Xem thêm: Uống dầu cá quanh năm được không hay phải ngắt quãng?
Xử lý nước máy ra sao để vừa đảm bảo an toàn, vừa không làm mất các khoáng chất tự nhiên có lợi?
ThS.BS. Võ Thị Tố Hi khuyến cáo, để đảm bảo an toàn mà vẫn giữ được các khoáng chất tự nhiên, người dân có thể áp dụng một số biện pháp sau:
- Đun sôi và để nguội đúng cách: đun sôi ít nhất 1-2 phút để diệt khuẩn, sau đó để nguội tự nhiên. Không nên để quá 24 giờ vì có thể tái nhiễm khuẩn từ môi trường.
- Dùng thiết bị lọc nước đạt chuẩn: nên chọn loại có lõi than hoạt tính hoặc gốm sứ, giúp loại bỏ clo và kim loại nặng nhưng vẫn giữ khoáng chất như canxi, magie.
- Lọc bằng than hoạt tính hoặc gốm: giúp loại bỏ clo, kim loại nặng, giữ được phần lớn khoáng tự nhiên.
- Với nguồn nước có TDS cao (>500 ppm): nên dùng máy lọc RO hoặc Nano có lõi bổ sung khoáng để duy trì cân bằng điện giải và hỗ trợ sức khỏe xương, miễn dịch.
- Bảo trì định kỳ: thay lõi lọc mỗi 3-6 tháng tùy chất lượng nước; vệ sinh bình chứa và đường ống lọc để tránh tái nhiễm khuẩn.
- Kiểm định định kỳ: người dân có thể mang mẫu nước đến Trung tâm y tế dự phòng hoặc Viện Pasteur để xét nghiệm clo dư, E. coli và kim loại nặng mỗi 6-12 tháng.
Nếu có biểu hiện rối loạn tiêu hóa kéo dài, mệt mỏi, hoặc nghi ngờ nhiễm độc nước, nên đi khám tại các chuyên khoa Dinh dưỡng hoặc Tiêu hóa để được đánh giá và hướng dẫn cụ thể.
Bệnh viện Gia An 115 là bệnh viện đa chuyên khoa kỹ thuật cao. Bệnh viện quy tụ đội ngũ chuyên gia, bác sĩ chuyên môn cao, dày dặn kinh nghiệm, tận tâm, chu đáo và hệ thống trang thiết bị hiện đại, đặc biệt có ứng dụng trí tuệ nhân tạo trong chẩn đoán, điều trị. Để đăng ký khám và tư vấn, Quý Khách hàng vui lòng liên hệ Tổng đài tư vấn 028.62.885.886 (trong giờ hành chính) - 0916.542.436 (ngoài giờ hành chính) hoặc sử dụng tính năng Đặt lịch khám ngay trên website.